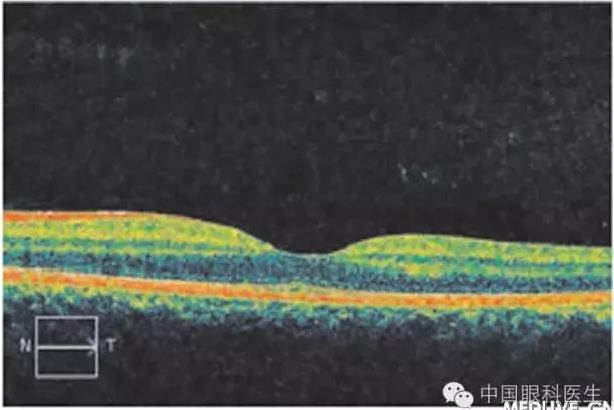
��������11���к������� ��Ϊ��Ĥ��ɫ֢

患者男,11岁。因于学校体检时发现双眼视力差,2个月于2010年8月10日来我院就诊。患者无家族病史,足月顺产,父母均为汉族,非近亲联姻。发育及智力正常,平素身体健康。全身皮肤、毛发与正常人相同。全身检查未见其他异常。
眼科检查:视力右眼为0.4,左眼为0.5;矫正视力右眼+5.25/+1.5×700 =0.6,左眼+4.75/+2.0×1100 =0.80眼压正常,色觉、立体视觉正常。双眼角膜透明,前房中深,双侧瞳孔直径约4nun,对光反射灵敏。右眼瞳孔区呈红色反光,虹膜呈淡褐色,色泽明显淡于左眼(图1).晶状体及玻璃体透明,眼底呈橙红色,视乳头红色与周围红色难于分清,中周部脉络膜血管清晰透见(图2)。左眼前节及眼底未见明显异常(图3)。光学相干断层扫描检查(OCT)示双眼黄斑区未见明显异常(图4、5)。
图1有眼虹膜呈淡褐色,色泽明显淡于左眼
图2右眼底呈橙红色,视乳头红色与周围红色难于分清,黄斑中心 凹反光不清,中周部脉络膜脉络膜血管清晰透见。
图3左眼底未见异常
左眼OCT未见明显异常
|